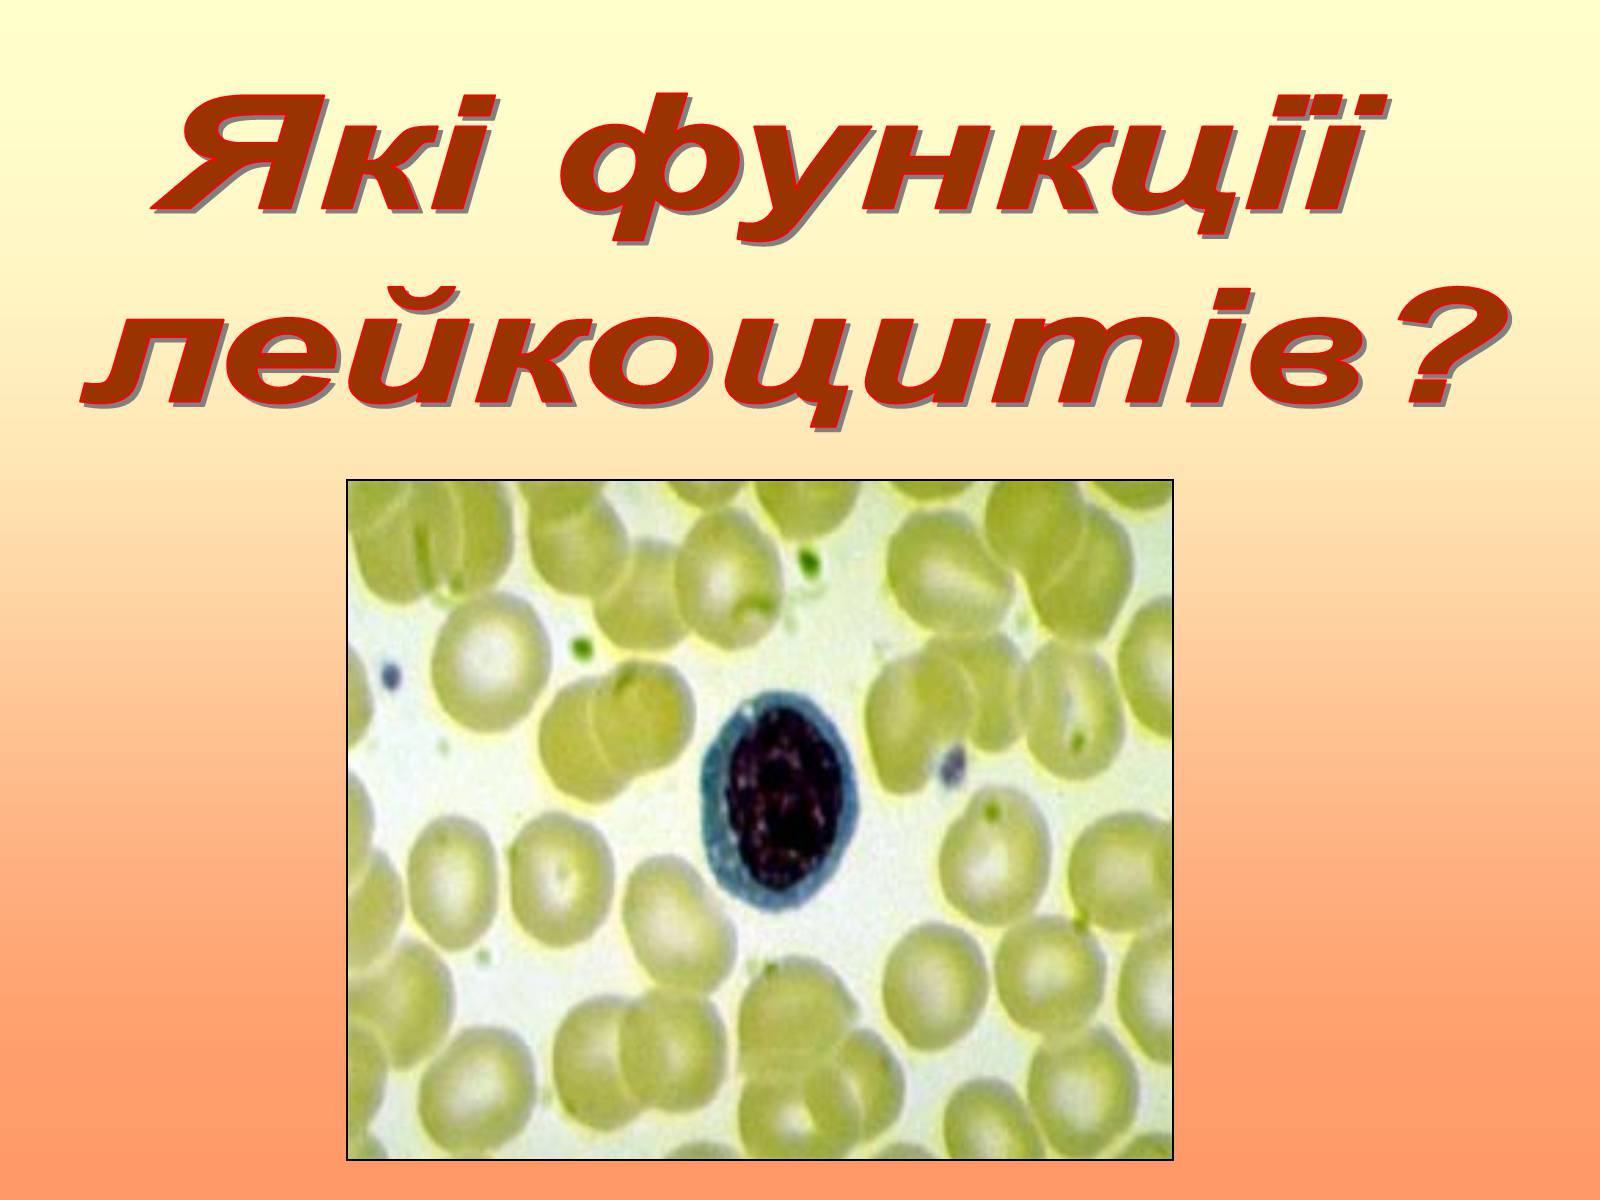

- Головна
- Готові шкільні презентації
- Презентація на тему «Кров» (варіант 2)
Презентація на тему «Кров» (варіант 2)
173
Поділитись підручником в соціальних мережах
Слайд #1
К
Виконала учениця 9-А класу:
Татарен Богдана.
Р
В
О
Виконала учениця 9-А класу:
Татарен Богдана.
Р
В
О

Слайд #2
Які рідини належать
до внутрішнього рідкого
середовища організму?
до внутрішнього рідкого
середовища організму?

Слайд #3
Внутрішнє середовище організму
Лімфа
Тканинна рідина
Кров
Складають рідини, які взаємодіють між собою, і за допомогою яких в організмі відбуваються всі важливі фізіологічні процеси. До них належать:
Лімфа
Тканинна рідина
Кров
Складають рідини, які взаємодіють між собою, і за допомогою яких в організмі відбуваються всі важливі фізіологічні процеси. До них належать:

Слайд #4
Кров рухається по замкнутих судинах і з клітинами тіла не контактує. Тканинна рідина утворюється з рідкої частини крові. Лімфа утворюється з тканинної рідини.
Внутрішнє середовище організму
Внутрішнє середовище організму

Слайд #5
Скільки крові
міститься
в організмі
дорослої людини?
міститься
в організмі
дорослої людини?

Слайд #6
Кров - рідка сполучна тканина.
В організмі дорослої людини міститься 5-6 л крові. Її об'єм становить 6-8% маси тіла.
В організмі дорослої людини міститься 5-6 л крові. Її об'єм становить 6-8% маси тіла.

Слайд #7
Кров під мікроскопом
Кров - рідка сполучна тканина.
Кров - рідка сполучна тканина.

Слайд #8
Який склад крові?

Слайд #9
Склад крові

Слайд #10
Склад крові
Плазма - 60%
Формені елементи - 40%:
- еритроцити;
- лейкоцити;
- тромбоцити.
Плазма - 60%
Формені елементи - 40%:
- еритроцити;
- лейкоцити;
- тромбоцити.

Слайд #11
Склад крові

Слайд #12
Склад крові
Формені елементи
еритроцити
лейкоцити
тромбоцити
Формені елементи
еритроцити
лейкоцити
тромбоцити

Слайд #13
Що таке
плазма крові?
плазма крові?

Слайд #14
Склад крові
Плазма крові
Виконує роль міжклітинної рідини. Вона містить 91% води і 9% розчине-них в ній речовин: білків, вуглеводів, амінокислот, жирів, глюкози, гормонів, мінеральних солей, мікроелементів, вітамінів…
Мінеральні речовини становлять 0,9%. Вони подані катіонами та аніонами: Na, K, Ca, Cl, HCO3, HPO4…
Плазма крові
Виконує роль міжклітинної рідини. Вона містить 91% води і 9% розчине-них в ній речовин: білків, вуглеводів, амінокислот, жирів, глюкози, гормонів, мінеральних солей, мікроелементів, вітамінів…
Мінеральні речовини становлять 0,9%. Вони подані катіонами та аніонами: Na, K, Ca, Cl, HCO3, HPO4…

Слайд #15
Що таке еритроцити?

Слайд #16
Склад крові
Еритроцити
Дрібні без'ядерні клітини d=7,5 мкм. Їх кількість в 1 куб. мм крові становить 5-5,5 млн.
Форма нагадує двоввігнутий диск, що сприяє кращому проникненню в них кисню.
Еритроцити
Дрібні без'ядерні клітини d=7,5 мкм. Їх кількість в 1 куб. мм крові становить 5-5,5 млн.
Форма нагадує двоввігнутий диск, що сприяє кращому проникненню в них кисню.

Слайд #17
Склад крові
Еритроцити
Еритроцити

Слайд #18
Скільки живуть
еритроцити?
Де вони утворюються
і руйнуються?
еритроцити?
Де вони утворюються
і руйнуються?

Слайд #19
Склад крові
Еритроцити
Живуть еритроцити близько 120 днів. Потім руйнуються у печінці і селезінці.
Кров постійно поповнюється новими клітинами, що утворюються у червоному кістковому мозку з особливих клітин, які називаються стовбуровими.
Еритроцити
Живуть еритроцити близько 120 днів. Потім руйнуються у печінці і селезінці.
Кров постійно поповнюється новими клітинами, що утворюються у червоному кістковому мозку з особливих клітин, які називаються стовбуровими.

Слайд #20
Склад крові
Дозрівання еритроцитів
Дозрівання еритроцитів

Слайд #21
Які функції
виконують
еритроцити?
виконують
еритроцити?

Слайд #22
Функції еритроцитів
Основна функція еритроцитів – постачання кисню до кожної клітини.
Вони переносять його від легень до клітин, а вуглекислий газ від клітин до легень.
Основна функція еритроцитів – постачання кисню до кожної клітини.
Вони переносять його від легень до клітин, а вуглекислий газ від клітин до легень.

Слайд #23
Газообмін між легенями,
тканинами та кров'ю
тканинами та кров'ю

Слайд #24
Що таке
гемоглобін?
гемоглобін?

Слайд #25
Склад крові
Гемоглобін
До складу еритроцитів входить гемоглобін. Він складається із залізо-
вмісної частини – гему та білкової частини – глобіну. Сполука гемоглобіну з киснем називається оксигемоглобін – HbO2, а з вуглекислим газом – HbCO2 – карбгемоглобін.
Гемоглобін
До складу еритроцитів входить гемоглобін. Він складається із залізо-
вмісної частини – гему та білкової частини – глобіну. Сполука гемоглобіну з киснем називається оксигемоглобін – HbO2, а з вуглекислим газом – HbCO2 – карбгемоглобін.

Слайд #26
Склад крові
Гемоглобін
Гемоглобін

Слайд #27
Що таке лейкоцити?

Слайд #28
Склад крові
Лейкоцити
Безбарвні клітини крові амебоїдної форми, що мають ядро. В 1 куб.мм крові їх 6-8 тис.
За будовою вони не однакові. У цитоплазмі деяких наявні зернятка, їх називають зернистими. Існують невеликі, з темним ядром – лімфоцити.
Лейкоцити
Безбарвні клітини крові амебоїдної форми, що мають ядро. В 1 куб.мм крові їх 6-8 тис.
За будовою вони не однакові. У цитоплазмі деяких наявні зернятка, їх називають зернистими. Існують невеликі, з темним ядром – лімфоцити.

Слайд #29
Склад крові
Лейкоцити
Лейкоцити

Слайд #30
Де утворюються
лейкоцити?
Який термін життя
лейкоцитів?
лейкоцити?
Який термін життя
лейкоцитів?

Слайд #31
Склад крові
Лейкоцити
Утворюються лейкоцити у червоному кістковому мозку, селезінці, лімфатичних вузлах. Тривалість їх життя від кількох днів до кількох тижнів, а деякі живуть до 10 років.
Лейкоцити
Утворюються лейкоцити у червоному кістковому мозку, селезінці, лімфатичних вузлах. Тривалість їх життя від кількох днів до кількох тижнів, а деякі живуть до 10 років.

Слайд #32
Склад крові
Види лейкоцитів
Види лейкоцитів

Слайд #33
Співвідношення між різними лейкоцитами у крові людини - це лейкоцитарна формула.
Склад крові
Види лейкоцитів
Склад крові
Види лейкоцитів

Слайд #34
Склад крові
Види лейкоцитів
Види лейкоцитів

Слайд #35
Які функції
лейкоцитів?
лейкоцитів?
Слайд #36
Функції лейкоцитів
Основна функція лейкоцитів – захист організму від бактерій, вірусів та інших чужорідних речовин.
Процес поглинання та перетравлю-
вання лейкоцитами різних сторонніх
частин носить назву
фагоцитоз, який був
відкритий І.І.Мєчніковим,
за що учений отримав
Нобелівську премію.
Основна функція лейкоцитів – захист організму від бактерій, вірусів та інших чужорідних речовин.
Процес поглинання та перетравлю-
вання лейкоцитами різних сторонніх
частин носить назву
фагоцитоз, який був
відкритий І.І.Мєчніковим,
за що учений отримав
Нобелівську премію.

Слайд #37
Функції лейкоцитів
Фагоцитоз
Фагоцитоз

Слайд #38
Загоювання ран
Функції лейкоцитів
Функції лейкоцитів

Слайд #39
Що таке тромбоцити?

Слайд #40
Склад крові
Тромбоцити
Тромбоцити – кров'яні пластинки, найдрібніші формені елементи d=1,5-2 мкм. В 1 л крові 200-400 10 . Усього в організмі 1,5 трлн. тромбоцитів.
Тромбоцити
Тромбоцити – кров'яні пластинки, найдрібніші формені елементи d=1,5-2 мкм. В 1 л крові 200-400 10 . Усього в організмі 1,5 трлн. тромбоцитів.

Слайд #41
Склад крові
Тромбоцити
Тромбоцити

Слайд #42
Які функції
тромбоцитів?
тромбоцитів?

Слайд #43
Функції тромбоцитів
Основна функція тромбоцитів – участь у зсіданні крові. Це захисна реакція, спрямована на зупинку кровотечі.
Основна функція тромбоцитів – участь у зсіданні крові. Це захисна реакція, спрямована на зупинку кровотечі.

Слайд #44
Розчинний білок фібриноген перетворюється у нерозчинний фібрин:
Фібриноген + Са2+ Фібрин
Ферменти тромбоцитів
Утворення тромбу
Функції тромбоцитів
Фібриноген + Са2+ Фібрин
Ферменти тромбоцитів
Утворення тромбу
Функції тромбоцитів

Слайд #45
Склад крові
Утворення тромбу
Утворення тромбу

Слайд #46
Які функції виконує кров?

Слайд #47
Функції крові
Транспортна функція включає:
Живильну – транспортування поживних речовин від органів травлення до клітин тіла.
Дихальну – полягає у перенесенні кисню від легень до клітин, а вуглекислого газу від клітин до органів дихання.
Видільну – перенесення від клітин до органів виділення продуктів обміну, надлишку води та мінеральних солей.
Транспортна функція включає:
Живильну – транспортування поживних речовин від органів травлення до клітин тіла.
Дихальну – полягає у перенесенні кисню від легень до клітин, а вуглекислого газу від клітин до органів дихання.
Видільну – перенесення від клітин до органів виділення продуктів обміну, надлишку води та мінеральних солей.

Слайд #48
Функції крові
Регуляторна функція забезпечується перенесенням гормонів та інших біологічно активних речовин від місця їх утворення до усіх клітин тіла.
Терморегуляторна полягає у підтри-
манні постійної температури тіла.
Захисна – кров бере участь у захисті організму від отруйних речовин, вірусів, мо та утворює тромб під час поранень.
Регуляторна функція забезпечується перенесенням гормонів та інших біологічно активних речовин від місця їх утворення до усіх клітин тіла.
Терморегуляторна полягає у підтри-
манні постійної температури тіла.
Захисна – кров бере участь у захисті організму від отруйних речовин, вірусів, мо та утворює тромб під час поранень.

Слайд #49
Які групи крові
наявні у людини?
наявні у людини?

Слайд #50
Переливання крові
Група крові залежить від наявності в еритроцитах білків-аглютиногенів та в плазмі крові білків-аглютининів.
Група крові залежить від наявності в еритроцитах білків-аглютиногенів та в плазмі крові білків-аглютининів.

Слайд #51
Які правила
переливання
крові?
переливання
крові?

Слайд #52
Переливання крові
- І група – універсальний донор, може давати кров усім іншим групам.
- ІІ група може давати ІІ та ІV.
- ІІІ група може давати ІІІ та ІV.
- ІV група – універсальний реціпієнт, може лише приймати кров від інших.
- І група – універсальний донор, може давати кров усім іншим групам.
- ІІ група може давати ІІ та ІV.
- ІІІ група може давати ІІІ та ІV.
- ІV група – універсальний реціпієнт, може лише приймати кров від інших.

Слайд #53
Що таке реакція
аглютинації?
аглютинації?

Слайд #54
Переливання крові
Реакція аглютинації – склеювання еритроцитів
Реакція аглютинації – склеювання еритроцитів

Слайд #55
Переливання крові

Слайд #56
Що таке резус-фактор?

Слайд #57
Переливання крові
Резус-належність – це наявність на мембрані еритроцитів білка – резус-фактора.
Людей, що мають такий білок називають резус-позитивними, їх 86%, а тих, що не мають даного білка називають резус-негативними, їх 14%.
Резус-належність – це наявність на мембрані еритроцитів білка – резус-фактора.
Людей, що мають такий білок називають резус-позитивними, їх 86%, а тих, що не мають даного білка називають резус-негативними, їх 14%.

Слайд #58
Що таке
резус-конфлікт?
резус-конфлікт?

Слайд #59
Переливання крові
Резус-конфлікт виникає, коли мати є резус-негативною, а дитина – резус-позитивною. У крові матері з'являються антитіла – специфічні білки, які руйнують еритроцити матері або дитини.
Резус-конфлікт виникає, коли мати є резус-негативною, а дитина – резус-позитивною. У крові матері з'являються антитіла – специфічні білки, які руйнують еритроцити матері або дитини.

Слайд #60
Бережіть себе і
свою планету!
Здоров'я кожного -
це здорова планета!
свою планету!
Здоров'я кожного -
це здорова планета!
